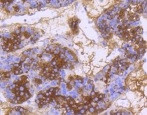
DNAJC15 Antibody in Immunohistochemistry (Paraffin) (IHC (P))

Search
Abnova
DNAJC15 Recombinant Rabbit Monoclonal Antibody
{{$productOrderCtrl.translations['antibody.pdp.commerceCard.promotion.promotions']}}
{{$productOrderCtrl.translations['antibody.pdp.commerceCard.promotion.viewpromo']}}
{{$productOrderCtrl.translations['antibody.pdp.commerceCard.promotion.promocode']}}: {{promo.promoCode}} {{promo.promoTitle}} {{promo.promoDescription}}. {{$productOrderCtrl.translations['antibody.pdp.commerceCard.promotion.learnmore']}}
产品信息
RAB02739
种属反应
宿主/亚型
Expression System
分类
类型
偶联物
形式
纯化类型
保存液
内含物
保存条件
运输条件
靶标信息
DNAJC15 is a negative regulator of the mitochondrial respiratory chain. DNAJC15 prevents mitochondrial hyperpolarization state and restricts mitochondrial generation of ATP. DNAJC15 also acts as an import component of the TIM23 translocase complex, and stimulates the ATPase activity of HSPA9. Diseases associated with DNAJC15 include Cicatricial Entropion.
仅用于科研。不用于诊断过程。未经明确授权不得转售。
篇参考文献 (0)
生物信息学
蛋白别名: Cell growth-inhibiting gene 22 protein; DnaJ (Hsp40) homolog, subfamily C, member 15; DnaJ (Hsp40) homolog, subfamily D, member 1; DNAJ domain-containing; DnaJ homolog subfamily C member 15; GIG22; MCJ; Methylation-controlled J protein; unnamed protein product
基因别名: 1110003P16Rik; DNAJC15; DNAJD1; GIG22; HSD18; MCJ
UniProt ID: (Human) Q9Y5T4, (Mouse) Q78YY6
Entrez Gene ID: (Human) 29103, (Rat) 290370, (Mouse) 66148